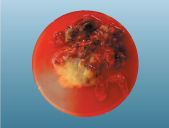

流死産絨毛・胎児組織(POC)染色体分析
POC染色体分析とは
- POCとは
- 胎盤絨毛組織や胎児組織はいずれも胎児に由来しており、総称してPOC (Products of Conception)と呼んでいます。
- POC染色体分析の有用性
- 流産は全妊娠の10~15%に発生しますが、約半数以上は染色体異常が原因であるとされています。POC染色体分析では染色体異常の有無やその種類を診断することが可能で、流死産の原因究明の一助となるだけでなく、その後の妊娠の治療方針を考える上でも重要な情報となります。2),3)
- POC染色体分析の意義
- POC染色体分析では、流産や死産において最も頻度の高い染色体異常を検出することが可能です。1)
- 流死産の原因が明らかになることにより、患者ご夫婦の精神的負担が軽減される場合があります。
- 流死産を繰り返した場合、不育症検査の必要性を判断することができます。
一般に絨毛染色体異常が検出されると母体要因の検索の必要性は少なくなります。 - 不育症の治療を行っていた場合など、流死産絨毛染色体異常の有無は今後の治療を考える上で非常に有用な情報となります。
- 適応例
-
- 患者ご夫婦が流産や死産の原因検索を希望される場合
- 不育症患者などで、今後の妊娠を考える場合
- 留意事項
- POC染色体分析は遺伝学的検査です。検査実施の前には患者ご夫婦へのインフォームドコンセントが必要です。結果をお話される際も遺伝カウンセリングを十分に行ってください。「患者ご夫婦へのご説明にあたって」に、簡単に説明の概要を示します。
ラボコープのPOC染色体分析
- 組織専用搬送容器
- 本検査のために弊社が独自に開発した溶液が含まれている組織専用容器です。
- 胎児絨毛組織の選別
- POC染色体分析では、POC検体から胎児絨毛組織のみを選択して培養することが重要で、培養した組織内に脱落膜が混入すると正確な判定が出来ない可能性があります。そのため提出された検体が脱落膜のみで胎児絨毛組織が見出されない場合は、検査をキャンセルさせて頂くこともあります。また結果が正常女性核型(46,XX)であった場合は、母体細胞が混入した可能性を完全には否定できないことになります。弊社のPOC染色体分析における正常核型の男女比は、1.000:1.086となっています(参考データ:染色体異常の頻度を参照)。
- 高い培養成功率
- POC検体全体での培養成功率は85%以上です。絨毛検体では90.0%となっています(参考データ:組織別の培養成功率を参照)
- 培養不可組織へのSNPマイクロアレイ
- 弊社ではPOC検体でのSNPマイクロアレイも提供しています。SNPマイクロアレイは組織を培養することなくPOC検体に直接的に検査を実施することができるため、検査の成功率が向上します。
- POC染色体分析が培養不成功となって患者様に結果を報告できなかった場合に有用です。
- 細菌汚染の疑いがある検体でも分析可能例があります。
- 豊富な経験と高い技術
- 米国臨床遺伝専門医会(American College of Medical Genetics: ACMG)等の認定取得者と、熟練した技術を持ち合わせた検査技師等が、検体処理ならびに結果の解析を行っています。
適切な検体とは
POC染色体分析では胎盤絨毛組織や胎児組織のすべてが検査対象となりますが、絨毛組織がもっとも培養成功率は高く、検体として適しています。
| 検体組織 | 注意事項 | 培養成功率 |
|---|---|---|
| 絨毛 | 絨毛組織を約50~100mg採取して下さい。 | 90% |
| 皮膚 | 腕や大腿部の皮膚を3~4mm角の大きさで採取して下さい。 筋肉や腱、硬い皮膚(踵など)は避けて下さい。 |
35~50% |
| 内臓 | 肝臓、肺、腎臓、胸腺を3~4mm角の大きさで採取して下さい。 | 20~45% |
検体の処理にあたって
染色体分析は、検体組織を培養して得られる分裂中の細胞を用いて行いますので、検体組織(細胞)が生存していることが必要となります。そのため検体処理にあたっては、下記の点に十分留意してください。
- 絨毛検体では、可能な限り脱落膜や母体血液を除去してください。
- 検体採取後は、できるだけ速やかに検体を提出してください。
- 細菌汚染を防ぐために、無菌操作あるいはそれに準ずる操作にて検体組織を処理してください。
- 弊社が提供する組織専用搬送容器にて提出してください。
- 検体量は絨毛検体の場合、50~100mgは必要です(ティースプーン1杯分)。
提出検体
以下の写真を参考に採取してください。


検体処理方法
以下の手順で無菌操作にて実施してください。
①準備するもの![]() |
|
|---|---|
②検体採取![]() |
採取した組織を直ちに生理食塩水の入ったシャーレに移し替えます。
|
③検体洗浄1![]() |
胎盤絨毛や胎児組織を識別するために、組織をピンセットでつまんで検体に付着した血液などを洗い流します。 |
④検体洗浄2![]() |
ピンセット等を用いて胎盤絨毛組織を選択して取り出し、検体洗浄用容器(緑ラベル)に入れて洗浄します。 検体洗浄用容器(緑ラベル)内の検体洗浄液をシャーレに移して、そこで検体を洗浄することも可能です。 |
⑤検体搬送用容器へ![]() |
④で洗浄した組織をティースプーン1杯分取り分け(50~100mg)、検体搬送容器(ピンクラベル)に入れます。 |
| ⑥提出 | 検査依頼書の下段にあるラベルに患者名(ローマ字)と採取日を記入し、提出する検体搬送容器に貼り付けます。検体回収まで冷蔵で保管してください。 |
- *1組織専用搬送容器が手元にない場合
細胞培養液もしくは平衡塩溶液(HankもしくはEarls)が入った滅菌済み容器をご利用ください。
可能であればペニシリン/ストレプトマイシン(100IU/ml/100μg/ml)もしくはゲンタマイシン(50μg/ml)を加えてください。 - *2組織専用搬送容器の有効期限が切れている場合
他の容器よりも弊社の専用容器をご利用頂くのが望ましいため、専用容器の期限が切れている場合でも、期限切れ容器をご利用ください。
患者ご夫婦へのご説明にあたって
POC染色体分析は遺伝学的検査です。検査実施の前には患者ご夫婦への遺伝カウンセリングを行い、インフォームドコンセントを取得してください。
POC染色体分析の前に
- <POC染色体分析とは>
-
- 自然流産の最大の原因は胎児側の染色体異常によるもので、POC染色体分析により染色体異常の有無や種類が判定できます。検出される異常としては、突発的に発生する数的異常(染色体の増減)が多く、トリソミーの頻度は母体年齢の上昇とともに増加します(参考データ:母体年齢と染色体異常の関係)。また構造異常(染色体構造の変化)が検出された場合は、患者ご夫婦のどちらかが構造異常(均衡型)を有していて、今後も同様の異常による流産が続く場合があります。
- 流死産を繰り返している場合は、染色体異常の有無はその後の妊娠の治療方針を考える上で重要な情報となります。
- <検査の限界>
-
- POC染色体分析では、流死産組織を培養して解析しますので、細胞のダメージが大きく培養が出来ずに終わった場合は結果が出ないことがあります。
- 微細な染色体異常や遺伝子レベルの変化など全ての遺伝学的異常を診断できるわけではありません。
- 検査開始前に胎児絨毛組織を可能な限り選別して培養を行いますが、残存した脱落膜細胞が増殖し、母体核型が検査結果として報告される場合があります。
- 提出された検体に絨毛組織が見出されない場合は、事前に検査をキャンセルさせて頂くこともあります。
結果の説明
検査結果に応じた説明の概要を簡単に示します。
- <正常核型の場合>
- 胎児側の染色体は正常であったことになり、染色体異常により流産が起こった可能性は否定的で、その他の母体側要因などにより流産が引き起こされたことになります。ただし、今回の検索では微細な染色体異常などすべての遺伝学的異常が検索できるわけではなく、正常女性核型(46,XX)であった場合は母体細胞混入の可能性も否定はできません。
- <異常核型の場合>
- 染色体異常が検出された場合は、流産の原因であった可能性は高いと考えられますので、その他の流産の原因となる母体側要因などの検索は必ずしも必要ではなくなります。染色体異常は1.数的異常と2.構造異常に分類されます。
- 数的異常の場合
トリソミーやモノソミーなどの異数体や倍数体などの異常に関しては、通常偶発的に生じたと考えられますので、今後も繰り返す可能性は低いと予想されます。そのため、次回妊娠の成功率が高いことも報告されています。ただし女性の加齢による影響は大きいので、早めに再び妊娠されることが望ましいでしょう。 - 構造異常の場合
構造異常には、転座、欠失、逆位などが含まれます。不均衡型の転座などが検出された場合は、患者ご夫婦のどちらかが均衡型の構造異常を有し、原因となっている場合があります。そのため患者ご夫婦自身の染色体分析が勧められています。検査前には、異常が検出された場合について、患者ご夫婦への遺伝カウンセリングを行い、インフォームドコンセントを取得してください。
患者ご夫婦の染色体分析で異常が認められた場合は、胎児の構造異常はご夫婦の染色体に由来することになります。ご夫婦が均衡型の構造異常を有していても、一般に染色体に過不足がないため特に異常が認められることはありませんが、染色体異常を有する精子や卵子が形成されることになるため、流産を繰り返したり異常児を出産したりする可能性が高くなることが考えられます。そのため専門家によるフォローが必要です。一方、患者ご夫婦に異常が認められない場合は、胎児の構造異常は突然変異により生じたと考えられますので、繰り返す可能性は低いと予想されます。
- 数的異常の場合
参考データ
2003年~2007年に弊社が受託した検体について結果をまとめました。
染色体異常の頻度
培養が成功して結果が得られた1477検体のうち、63.8%が異常核型でした。なお、正常核型の男女比は、男性:女性=1.000(256件):1.086(278件)となりました。
染色体異常の内訳
図2のように、染色体異常の約60%を常染色体トリソミーが占めていました。倍数体および性染色体異常がそれぞれ12%を占め、構造異常は5.5%でした。図3では常染色体トリソミーの内訳を示しています。頻度が高い順に16、22、21、15、18、13トリソミーでした。性染色体異常は90%以上が45,X(モザイク例を含む)でした。構造異常の内訳を表1に示しています。不均衡型の相互転座が構造異常の63.5%を占めていました。
| 件数 | 頻度 | |
|---|---|---|
| 相互転座 (均衡型) (不均衡型) |
36 (3) (33) |
69.2% (5.8%) (63.5%) |
| ロバートソン転座 (均衡型) (不均衡型) |
10 (2) (8) |
19.2% (3.8%) (15.4%) |
| 欠失 | 2 | 3.8% |
| 同腕染色体 | 2 | 3.8% |
| マーカー染色体 | 1 | 1.9% |
| 逆位 | 1 | 1.9% |
母体年齢と染色体異常の関係
図4のように、母体年齢が高くなるほど流産絨毛検体における染色体異常の割合が増加しました。40歳以上では染色体異常が80%以上を占めました。なお、35歳を基準とすると、35歳未満では染色体異常が54.9%、35歳以上では75.3%となり、35歳以上では染色体異常の割合が有意に高くなりました(p<0.001,CI95%)。
また図5のように、染色体異常に占める常染色体トリソミーの割合を比較したところ、35歳未満では47.9%、35歳以上では71.2%となり、35歳以上では常染色体トリソミーの割合が有意に高くなりました(p<1.001)
組織別の培養成功率
弊社米国検査所が1998年~2004年の6年間に検査を行った検体の組織別培養成功率は、絨毛検体が90%と最も高い成功率になりました(表2)。
| 検体組織 | 培養実施数 | 培養成功数 | 培養成功率(%) |
|---|---|---|---|
| 絨毛 | 28,291 | 25,461 | 90.0 |
| 羊膜または絨毛膜 | 373 | 295 | 79.1 |
| 臍帯 | 220 | 136 | 61.8 |
| 筋膜 | 50 | 30 | 60.0 |
| 肝臓 | 36 | 17 | 47.2 |
| 皮膚 | 3,882 | 1,708 | 44.0 |
| 肺 | 162 | 63 | 38.9 |
| 腱 | 21 | 8 | 38.1 |
| 胎児組織*1 | 257 | 92 | 35.8 |
| 器官*2 | 28 | 10 | 35.7 |
| 筋肉 | 416 | 146 | 35.1 |
| 腎臓 | 18 | 4 | 22.2 |
- *1組織を特定できない胎児組織
- *2器官を特定できない胎児組織
検体受託要項
| 検査項目名 | 流死産絨毛・胎児組織(POC)染色体分析 |
|---|---|
| 検体必要量 | 胎児絨毛組織:50~100mg その他胎児組織:3~4mm角 |
| 採取容器 | 組織専用搬送容器 |
| 検体の採取条件 |
|
| 保存温度 | 冷蔵 |
| 所要日数 | 14~21日 (ラボコープ・ジャパン受託日より起算) |
| 備考 |
|
参考文献
- Laurino MY, et al. Genetic evaluation and counseling of couples with recurrent miscarriage: Recommendations of the National Society of Genetic Counselors. J Genet Couns.2005;14:165-81.
- Carp H, et al. Embryonic karyotype of the abortus in recurrent miscarriage. Fertil Steril. 2001;75:678-682.
- Ogasawara M, et al. Embryonic karyotype of abortuses in relation to the number of previous miscariages. Fertil Steril. 2000;73:300-304.
通知等
- 日本医学会「医療における遺伝学的検査・診断に関するガイドライン」
- 日本産科婦人科学会 周産期委員会委員会報告(2021 年 6 月)
医療関係者用資料
- 流死産絨毛・胎児組織(POC)染色体分析 医療関係者用資料
- 流死産絨毛・胎児組織(POC)染色体分析 一般の方用資料
- 流死産絨毛・胎児組織(POC)染色体分析 報告書見本
- 流死産絨毛・胎児組織(POC)染色体分析 同意書ひな形
監修:国立病院機構 東京医療センター 産婦人科 小澤 伸晃 先生